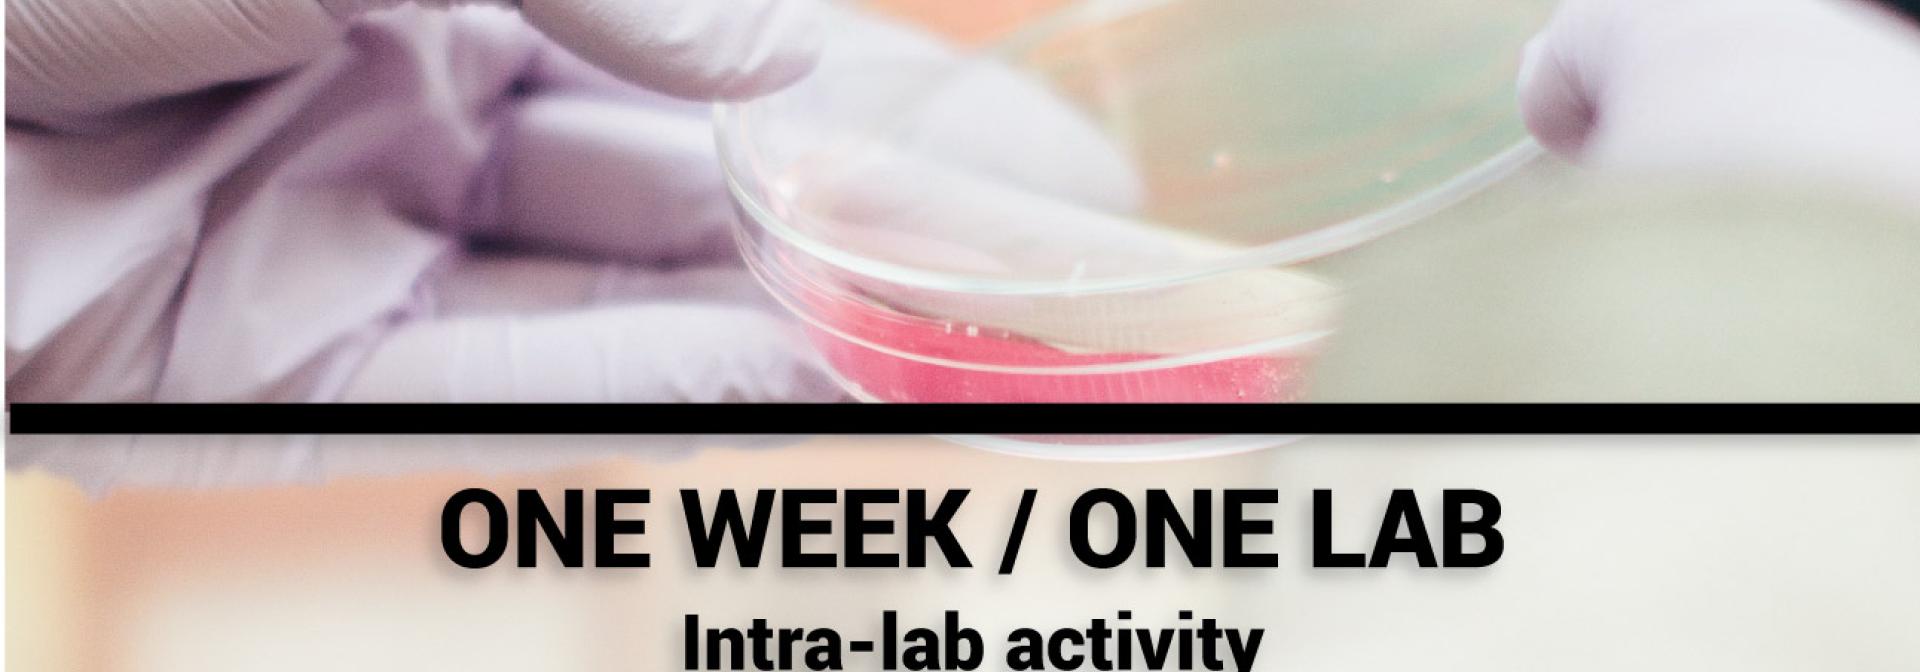
Generic representation of One Week / One Lab - Cellular and Inorganic Biochemistry Lab

|
Research Teams/Sites
|
Date |
When and where |
|
FBHRG - Fisheries, Biology and Hydroecology |
02 April |
9.30 - 12.00 (room 2.31) & 14.00 - 15.00 |
|
Ramalhete Marine Station |
02 April |
16.00 - 17.00 |
|
BEE - Biogeography, Ecology and Evolution |
04 April |
9.30 - 10.30 |
|
ALGAE - Marine Plant Ecology |
8 April |
9.30 - 10.30 |
|
IPMA Olhão |
11 April |
10.30 - 12.30 |
|
FishEthoGroup - Fish Ethology and Welfare |
16 April |
9.30 - 10.30 (Building 8, Lab 2.73) |
|
AquaGroup - Aquaculture |
23 April |
14.00 - 15.00 |
|
BIOSKEL - Comparative, adaptive and functional skeletal biology |
7 May |
9.30 - 10.30 |
|
CEIB - Comparative Endocrinology and Integrative Biology |
13 May |
9.30 - 10.30 |
|
ECOREACH - Ecology and Restoration of Estuarine and Coastal Habitats |
20 May |
9.30 - 10.30 |
|
FBP - Functional Biochemistry and Proteomics |
27 May |
9.30- 10.30 |
|
PSB - Plant Systematics and Bioinformatics |
31 May |
16.00 - 17.00 |
|
FBC - Fisheries, Biodiversity and Conservation |
3 June |
9.30 - 10.30 |
|
XtremeBio |
6 June |
9.30 - 10.30 |
|
MarBiotech - Marine Biotechnology |
11 June |
9.30 - 10.30 |
|
MMB - Marine Molecular Bioengineering |
17 June |
9.30 - 10.30 |
|
OrgMedChem - Organic Reactivity and Medicinal Chemistry |
24 June |
9.30- 10.30 |